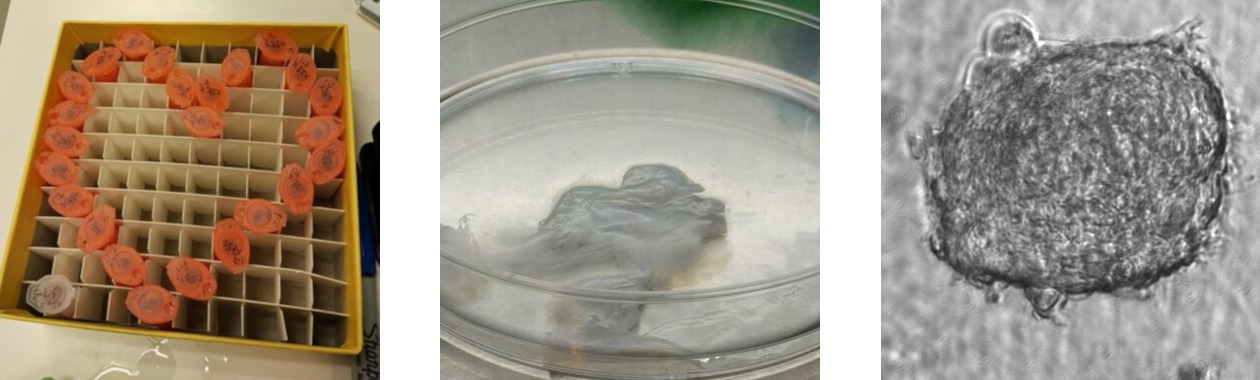
schleslab-banner-lab.jpg schleslab-banner-lab.jpg

Dr. Sharon Elizur-Schlesinger
There is something profoundly elegant about the way a single cell becomes many. From the quiet, unassuming zygote emerges a world of possibility: muscle, neuron, skin, blood. Each choice, each transformation, carries the weight of billions of years of evolution, refined by time, governed by an intricate molecular logic.
And yet, what truly defines a cell’s identity? What unseen forces decide its fate? In development, in disease, in every breath we take, cells shift, adapt, and respond. At times, the rules seem clear—epigenetic markers, transcriptional programs, lineage constraints. But then, the unexpected happens. A cell defies its prescribed destiny, reprograms itself, chooses another path. Why?
This is the frontier where we work.
At the Schlesinger Lab, we seek not just to understand, but to uncover the deeper principles governing cellular identity. We follow the signals, the environmental cues, the stressors that nudge a cell toward one fate or another. We ask:
- What makes the epigenetic landscape of stem cells uniquely poised for change?
- How do external pressures—chemical, physical, environmental—reshape the fate of a cell?
- How can we use these insights to expand our understanding of cell biology and its applications?
Cells don’t make decisions in isolation—just as we, as scientists, do not work in isolation. The forces that shape a cell’s identity are complex, and to understand them, we need to look beyond individual factors. By studying the interplay between intrinsic regulation and external influence, we move closer to answering fundamental biological questions.
Every experiment brings us one step closer to untangling the rules of cellular identity. With better knowledge of how cell fate is determined, we can push biology forward—not just for the sake of discovery, but for applications that may impact medicine, agriculture, biotechnology, and the broader understanding of life itself.
Research Interests:
Join the Journey